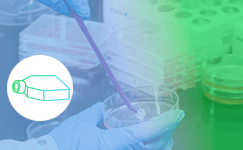
Cell-culture.png Cell-culture.png

Think It, Find It! Only at VWR Consumables.
ALL YOUR
LAB CONSUMABLE NEEDS
UNDER ONE ROOF!

Our solutions developed with you for your daily laboratory needs
A comprehensive selection of high-quality consumables with unmatched reliability for all your needs from liquid handling to lab safety, labware to cell culture.
Think It, Find It! Only at VWR Consumables.
Our value, our promise with VWR Consumables

Quality & choice

Customisation

Convenience

Expertise
AVANTOR IS THE EASY CHOICE FOR LAB CONSUMABLES SOLUTIONS
Avantor has more than 160 years of experience helping labs manage their equipment and supplies. We are a leading global provider of mission-critical products and services to customers in the biopharma, healthcare, education and government, and advanced technologies and applied materials industries.
Ready to move your next innovation forward?